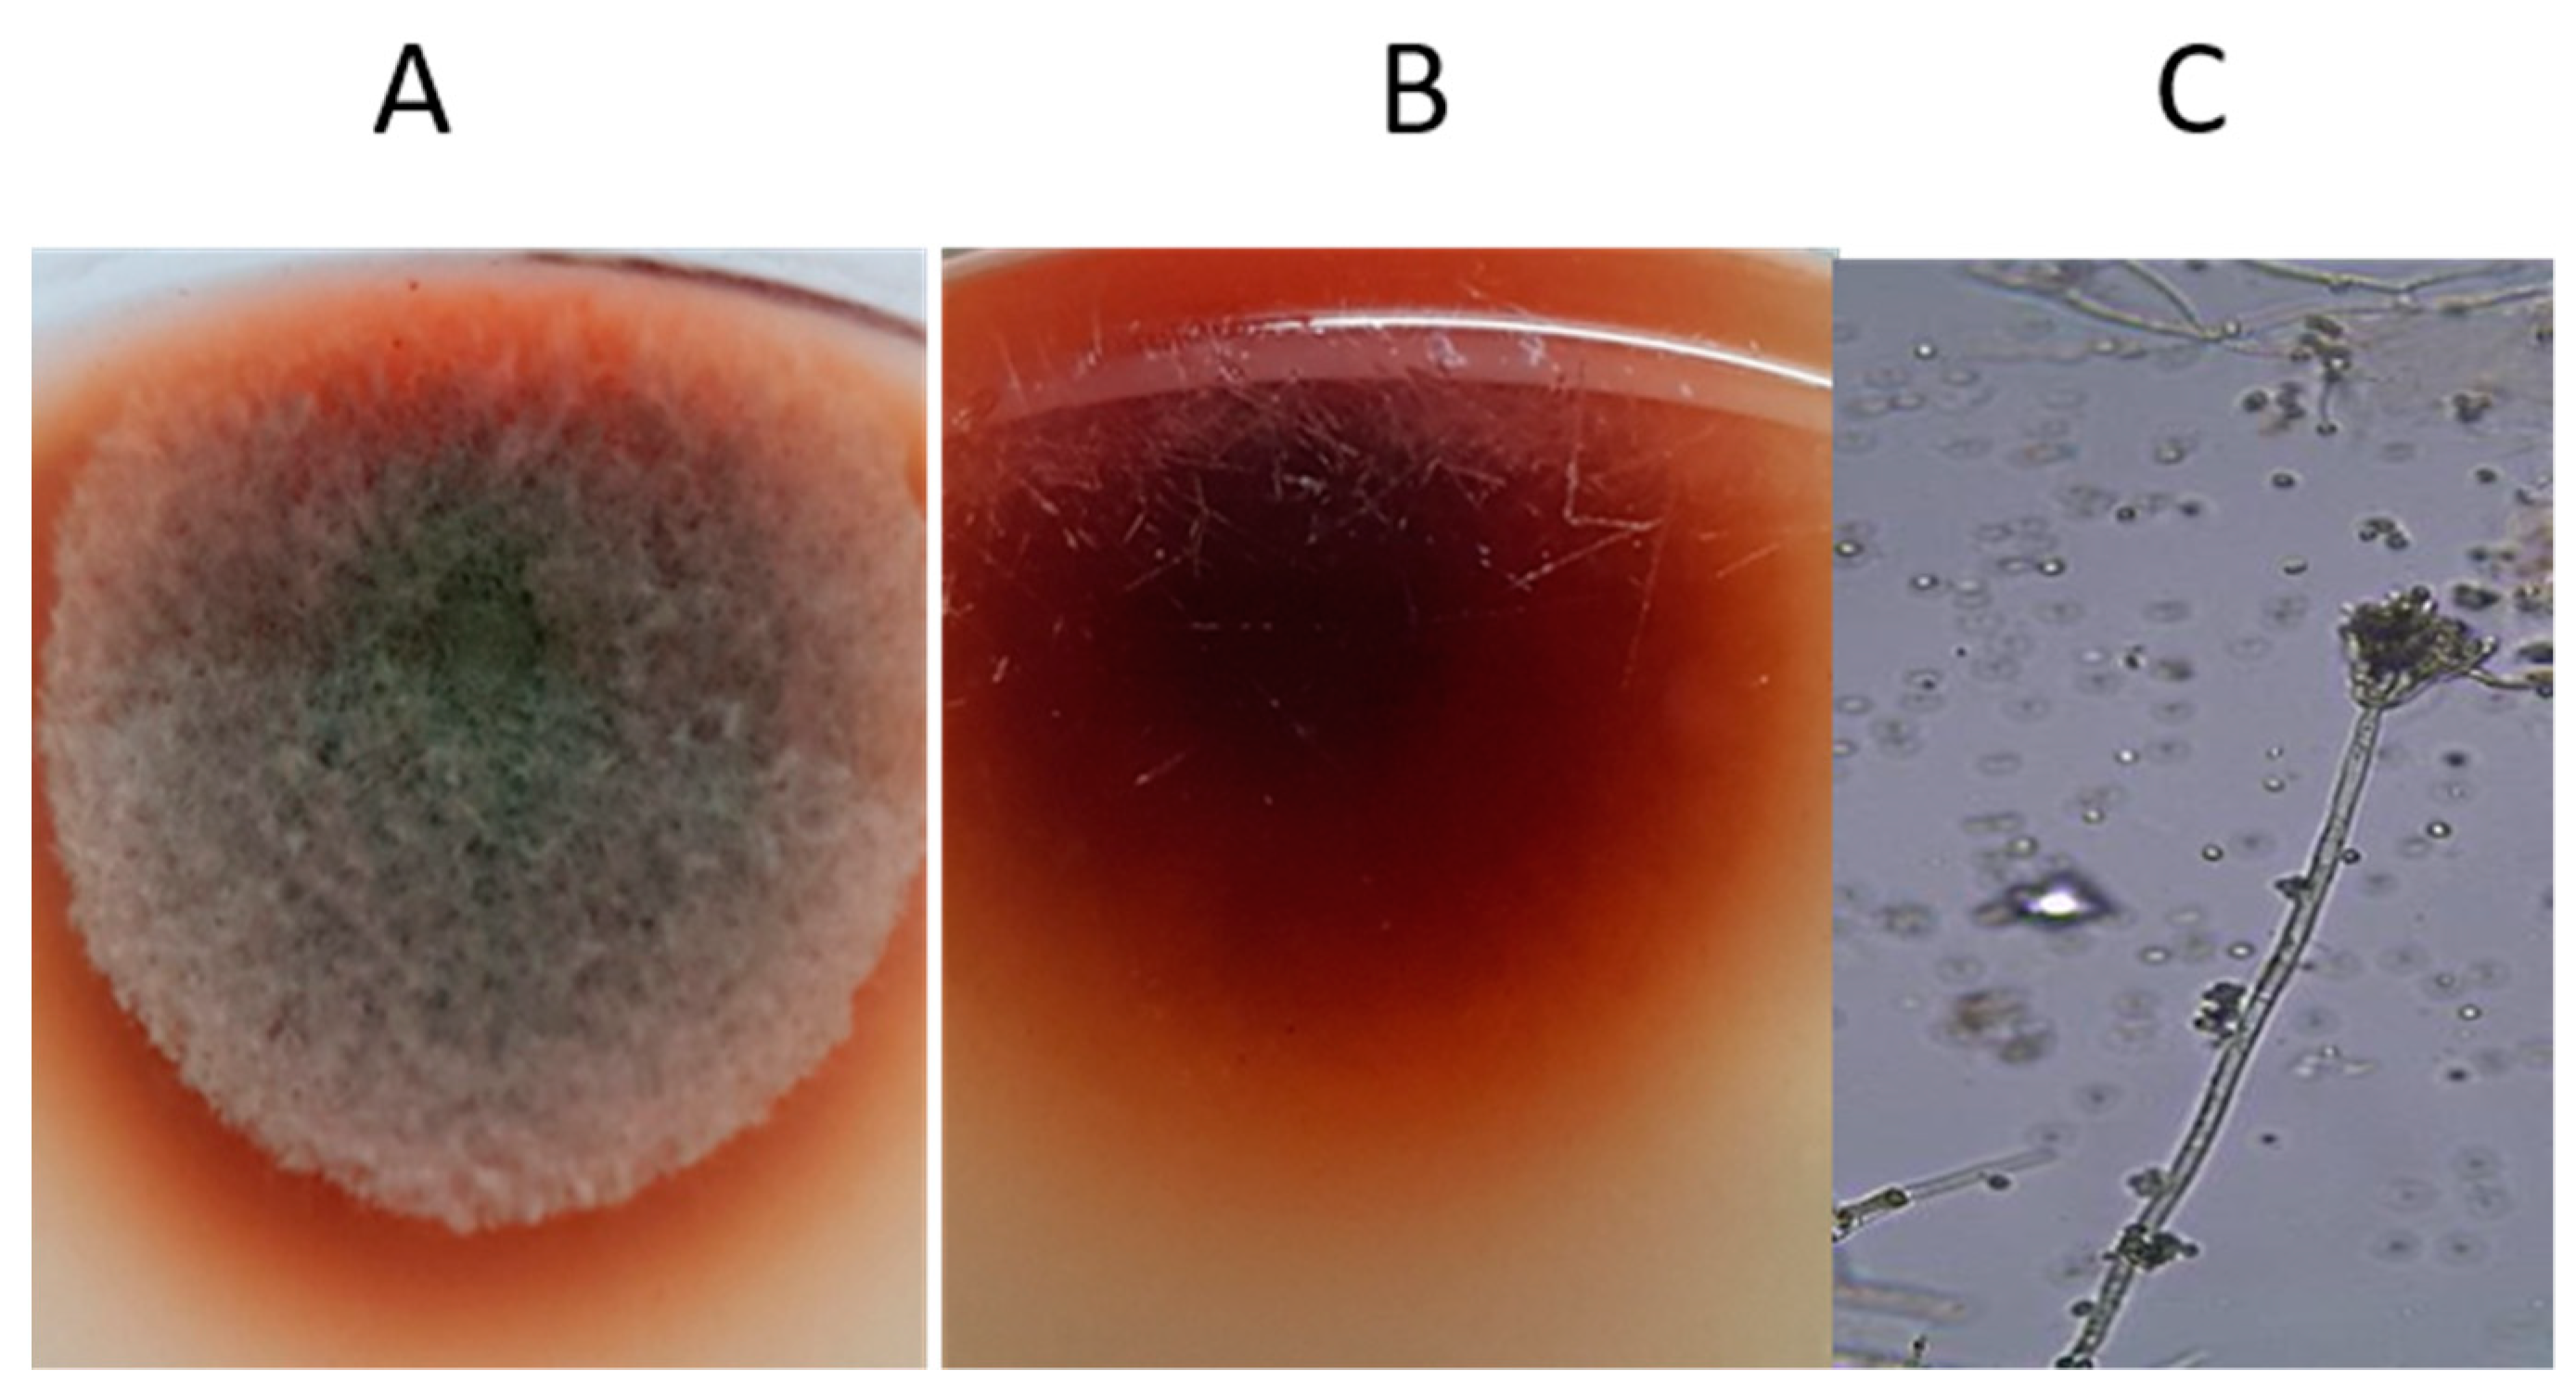

The Effect of Endophytic Talaromyces pinophilus on Growth, Absorption and Accumulation of Heavy Metals of Triticum aestivum Grown on Sandy Soil Amended by Sewage Sludge
Abstract
1. Introduction
2. Materials and Methods
2.1. Fungal Isolation and Identification
2.2. Morphological Identification of the Fungal Isolate
2.3. Molecular Identification
2.4. Fungal Inoculum Preparation
2.5. Extraction and Determination of Phytohormones
2.6. Plant Material and Growth Conditions
2.7. Determination of Growth Parameters
2.8. Determination of Photosynthetic Pigments
2.9. Determination of Organic Solutes
2.10. Antioxidant Enzymes Activity
2.11. Determination of Mineral Ions and Heavy Metals
2.12. Determination of the Bioconcentration Factor (BCF) and Translocation Factor (TF)
2.13. Statistical Analysis
3. Results
3.1. Isolation and Morphological Identification of the Fungal Isolate
3.2. Nucleotide Sequence Accession Number and Phylogenetic Analysis
3.3. Phytohormones
3.4. Water Content (WC) and Growth of T. aestivum Plants Grown on Different Sewage Sludge Levels and Phytoremediation by T. pinophilus
3.5. Photosynthetic Pigments of T. aestivum Plants Grown on Different Sewage Sludge Levels and Phytoremediation by T. pinophilus
3.6. Osmolytes of T. aestivum Plants Grown on Different Sludge Levels and Phytoremediation by T. pinophilus
3.7. Antioxidant Enzymes of T. aestivum Plants Grown on Different Sludge Levels and Phytoremediation by T. pinophilus
3.8. Translocation and Content of Minerals in Wheat Plant Cations
3.9. Effects of Sewage Sludge and T. pinophilus on Growth Media
3.10. The Content and Distribution of Heavy Metals in T. aestivum
4. Discussion
5. Conclusions
Author Contributions
Funding
Institutional Review Board Statement
Informed Consent Statement
Data Availability Statement
Conflicts of Interest
References
- Fadiji, A.E.; Babalola, O.O. Elucidating Mechanisms of Endophytes Used in Plant Protection and Other Bioactivities With Multifunctional Prospects. Front. Bioeng. Biotechnol. 2020, 8, 467. Available online: www.frontiersin.org (accessed on 15 May 2020). [CrossRef]
- Abbas, A.M.; Abd-Elmabod, S.K.; El-Ashry, S.M.; Soliman, W.S.; El-Tayeh, N.; Castillo, J.M. Capability of the Invasive Tree Prosopis glandulosa Torr. To Remediate Soil Treated with Sewage Sludge. Sustainability 2019, 11, 2711. [Google Scholar] [CrossRef]
- Khan, S.A.; Hamayun, M.; Khan, A.L.; Lee, I.J.; Shinwari, Z.K.; Kim, J. Isolation of plant growth promotic fungi from dicots inhabiting coastal sand dunes of Korea. J. Bot. 2012, 44, 1453–1460. [Google Scholar]
- Tumangger, B.S.; Nadilla, F.; Baiduri, N.; Mardina, F.V. In vitro Screening of Endophytic Fungi Associated with Mangroveas Biofertilizer on the Growth of Black Rice (Oryza sativaL. Cempo Ireng). In Proceedings of the 2nd Nommensen International Conference on Technology and Engineering IOP Publishing Materials Science and Engineering, Medan, Indonesia, 19–20 July 2018; ISBN 420012080. [Google Scholar] [CrossRef]
- Rigobelo, E.C.; Noemi Carla Baron, N.C. Endophytic fungi: A tool for plant growth promotion and sustainable agriculture. Mycology 2021, 1–17. [Google Scholar] [CrossRef]
- Ma, Y.; Prasad, M.N.V.; Rajkumar, M.; Freitas, H. Plant growth promoting rhizobacteria and endophytes accelerate phytoremediation of metalliferous soils. Biotechnol. Adv. 2011, 29, 248–258. [Google Scholar] [CrossRef]
- Pendergrass, A.; Butcher, D.J. Uptake of lead and arsenic in food plants grown in contaminated soil from Barber Orchard, NC. Microchem. J. 2006, 83, 14–16. [Google Scholar] [CrossRef]
- Baker, A.J.M.; Reeves, R.D.; McGrath, S.P. In Situ Decontamination of Heavy Metal Polluted Soils Using Crops of Metal-Accumulating Plants—A Feasibility Study. In Situ Bioreclam. 1991, 7, 600–605. [Google Scholar]
- Greipsson, S. Phytoremediation. Nat. Educ. Knowl. 2011, 3, 7. [Google Scholar]
- Rajkumar, M.; Ae, N.; Prasad, M.N.V.; Freitas, H. Potential of siderophore-producing bacteria for improving heavy metal phytoextraction. Trends Biotechnol. 2010, 28, 142–149. [Google Scholar] [CrossRef]
- Gerhardt, K.E.; Huang, X.D.; Glick, B.R.; Greenberg, B.M. Phytoremediation and rhizoremediation of organic soil contaminants: Potential and challenges. Plant Sci. 2009, 176, 20–30. [Google Scholar] [CrossRef]
- Glick, B.R. Using soil bacteria to facilitate phytoremediation. Biotechnol. Adv. 2010, 28, 367–374. [Google Scholar] [CrossRef] [PubMed]
- Rajkumar, M.; Sandhya, S.; Prasad, M.N.; Freitas, H. Perspectives of plant-associated microbes in heavy metal phytoremediation. Biotechnol. Adv. 2012, 30, 1562–1574. [Google Scholar] [CrossRef] [PubMed]
- Li, H.Y.; Li, D.W.; He, C.M.; Zhou, Z.P.; Mei, T.; Xu, H.M. Diversity and heavy metal tolerance of endophytic fungi from six dominant plant species in a Pb-Zn mine wasteland in China. Fungal Ecol. 2012, 5, 309–315. [Google Scholar] [CrossRef]
- Li, H.Y.; Shen, M.; Zhou, Z.P.; Li, T.; Wei, Y.L.; Lin, L.B. Diversity and cold adaptation of endophytic fungi from five dominant plant species collected from the Baima Snow Mountain, Southwest China. Fungal Divers. 2012, 54, 79–86. [Google Scholar] [CrossRef]
- Ren, A.Z.; Li, C.A.; Gao, Y.B. Endophytic fungus improves growth and metal uptake of Lolium Arundinaceum Darbyshire ex. Schreb. Int. J. Phytoremed. 2011, 13, 233–243. [Google Scholar] [CrossRef] [PubMed]
- Shahabivand, S.; Maivan, H.Z.; Goltapeh, E.M.; Sharifi, M.; Aliloo, A.A. The effects of root endophyte and arbuscular mycorrhizal fungi on growth and cadmium accumulation in wheat under cadmium toxicity. Plant Physiol. Biochem. 2012, 60, 53–58. [Google Scholar] [CrossRef]
- Khan, A.L.; Lee, I.J. Endophytic Penicillium funiculosum LHL06 secretes gibberellin that reprograms Glycine max L. growth during copper stress. BMC Plant Biol. 2013, 13, 86. [Google Scholar] [CrossRef]
- AbouAlhamed, M.F.; Shebany, Y.M. Endophytic Chaetomium globosum enhances maize seedling copper stress tolerance. Plant Biol. 2012, 14, 859–863. [Google Scholar] [CrossRef] [PubMed]
- Abdel-Hafez, S.I.I.; Abo-Elyousr, K.A.; Abdel-Rahim, I.R. Leaf surface and en- dophytic fungi associated with onion leaves and their antagonistic activity against Alternaria porri. Czech Mycol. 2015, 67, 1–22. [Google Scholar] [CrossRef]
- Zhao, W.T.; Shi, X.; Xian, P.J.; Feng, Z.; Yang, J.; Yang, X.L.; Zhao, W.T. A new fusicoccane diterpene and a new polyene from the plant endophytic fungus Talaromyces pinophilus and their antimicrobial activities. Nat Prod Res. 2021, 35, 124–130. [Google Scholar] [CrossRef] [PubMed]
- Zhai, M.M.; Niu, H.T.; Li, J.; Xiao, H.; Shi, Y.P.; Di, D.L.; Crews, P.W.Q. Talaromycolides A-C, Novel Phenyl-Substituted Phthalides Isolated from the Green Chinese Onion-Derived Fungus Talaromyces pinophilus AF-02. J. Agric. Food Chem. 2015, 63, 9558–9564. [Google Scholar] [CrossRef]
- Nicoletti, R.; Trincone, A. Bioactive compounds produced by strains of Penicillium and Talaromyces of marine origin. Mar. Drugs 2016, 14, 37. [Google Scholar] [CrossRef]
- Wang, M.-H.; Li, X.-M.; Li, C.-S.; Ji, N.-Y.; Wang, B.-G. Secondary metabolites from Penicillium pinophilum SD-272, a marine sediment-derived fungus. Mar. Drugs 2013, 11, 2230–2238. [Google Scholar] [CrossRef]
- Pitt, J.I. The Genus Penicillium and Its Teleomorphic States Eupenicillium and Talaromyces; Academic Press Inc. Ltd.: London, UK, 1979. [Google Scholar]
- Yilmaz, N.; Visagie, C.M.; Houbraken, J.; Frisvad, J.C.; Samson, R.A. Polyphasic taxonomy of the genus Talaromyces. Stud. Mycol. 2014, 78, 175–341. [Google Scholar] [CrossRef]
- Ausubel, F.; Brent, R.; Kingston, R.; Moore, D.; Seidman, J.; Smith, J.; Struhl, K. Current Protocols in Molecular Biology; Massachusetts General Hospital, Harvard Medical School: Cambridge, MA, USA, 1998. [Google Scholar]
- Abdel-Rahim, I.R.; Abo-Elyousr, K.A.M. Talaromyces pinophilus strain AUN-1 as a novel mycoparasite of Botrytis cinerea, the pathogen of onion scape and umbel blights. Microbiol. Res. 2018, 212, 1–9. [Google Scholar] [CrossRef] [PubMed]
- Saitou, N.; Nei, M. The neighbor-joining method: A new method for reconstructing phylogenetic trees. Mol. Biol. Evol. 1987, 4, 406–425. [Google Scholar] [PubMed]
- Tamura, K.; Nei, M.; Kumar, S. Prospects for inferring very large phylogenies by using the neighbor-joining method. Proc. Natl. Acad. Sci. USA 2004, 101, 11030–11035. [Google Scholar] [CrossRef]
- Kumar, S.; Stecher, G.; Lim, M.; Knyaz, C.; Tamura, K. MEGA X: Molecular Evolutionary Genetics Analysis across computing platforms. Mol. Biol. Evol. 2018, 35, 1547–1549. [Google Scholar] [CrossRef]
- Altschul, S.F.; Gish, W.; Miller, W.; Myers, E.W.; Lipmanl, D.J. Basic Local Alignment Search Tool. J. Mol. Biol. 1990, 215, 403–410. [Google Scholar] [CrossRef]
- Rachev, R.C.H.; Rousava, R.P.; Bojkova, S.V.; Gancheva, V.K. Isolation of gibberellic acid produced by Fusarium moniliforme. J. Nat. Prod. 1993, 56, 1168–1170. [Google Scholar] [CrossRef]
- Hoagland, D.R.; Arnon, D.I. The water culture method for growing plants without soil. Calif. Agric. Exp. Stn. 1950, 347, 32. [Google Scholar]
- Richards, L.A. Diagnosis and Improvement of Saline and Alkali Soils. In Handbook; US Department of Agriculture: Washington, DC, USA, 1954. [Google Scholar]
- Walkley, A.; Black, I.A. An examination of the Detjareff method for determining soil organic matter and a proposed modification of the chromic acid titration method. Soil Sci. 1934, 37, 29–38. [Google Scholar] [CrossRef]
- Metzner, H.; Rau, H.; Senger, H. Untersuchungezursynchronisierbarkarkeiteinzelner-pigmentmangle-mutanten von chlorella. Planta 1956, 65, 186–194. [Google Scholar] [CrossRef]
- Bradford, M.M. A rapid and sensitive method for the quantitation of microgram quantities of protein utilizing the principle of protein–dye binding. Anal. Biochem. 1976, 72, 248–254. [Google Scholar] [CrossRef]
- Moore, S.; Stein, W.H. Photometric nin-hydrin method for use in the chromatography of amino acids. J. Biol. Chem. 1948, 176, 367–388. [Google Scholar] [CrossRef]
- Irigoyen, J.; Einerich, D.; Sanche-Diaz, M. Water stress induced changes in concentrations of proline and total soluble sugars in nodulated alfalfa (Medicago sativa) plants. Physiol. Plant 1992, 84, 55–60. [Google Scholar] [CrossRef]
- Aebi, H. Catalase in vitro. Methods Enzymol. 1984, 105, 121–126. [Google Scholar]
- MacAdams, J.W.; Nelson, C.J.; Sharp, R.E. Peroxidase activity in the leaf elongation zone of tall fescue. Plant Physiol. 1992, 99, 872–878. [Google Scholar] [CrossRef]
- Beauchamp, C.; Fridovich, I. Superoxide dismutase: Improved assays and an assay applicable to acrylamide gels. Anal. Biochem. 1971, 44, 276–287. [Google Scholar] [CrossRef]
- Allen, S.E. Chemical Analysis of Ecological Materials, 2nd ed.; Blackwell Scientific Publications: Oxford, UK, 1989; p. 368. [Google Scholar]
- Williams, C.H.; Twine, M.E. Flame Photometric Method for Sodium, Potassium and Calcium. In Modern Methods of Plant Analysis; Paech, K., Tracey, M.V., Eds.; Springer-Verlag: Berlin, Germany, 1960; Volume 5, p. 535. [Google Scholar]
- Schwarzenbach, G.; Biedermann, W. Komplexonex. Erdalkalikomplexe van, o,6-Doxyazofarbstoffen He\v. Chem. Acta 1984, 31, 678–687. [Google Scholar] [CrossRef]
- Peterson, S.W.; Jurjevi, Z. The Talaromycespinophilus species complex. Fungal Biol. 2019, 123, 745–762. [Google Scholar] [CrossRef] [PubMed]
- Yoon, J.; Cao, X.; Zhou, Q.; Ma, L.Q. Accumulation of Pb, Cu, and Zn in native plants growing on a contaminated Florida site. Sci. Total Environ. 2006, 368, 456–464. [Google Scholar] [CrossRef]
- Gong, B.; Liu, G.; Liao, R.; Song, J.; Zhang, H. Endophytic fungus Purpureocillium sp. A5 protect mangrove plant Kandelia candel under copper stress. Braz. J. Microbiol. 2017, 48, 530–536. [Google Scholar] [CrossRef] [PubMed]
- Koul, M.; Meena, S.; Kumar, A.; Sharma, P.R.; Singamaneni, V.; Riyaz-Ul-Hassan, S.; Hamid, A.; Chaubey, A.; Prabhakar, A.; Gupta, P. Secondary metabolites from endophytic fungus Penicillium pinophilum induce ROS-mediated apoptosis through mitochondrial pathway in pancreatic cancer cells. Planta Med. 2016, 82, 344–355. [Google Scholar] [CrossRef]
- Yao, Y.Q.; Lan, F.; Qiao, Y.M.; Wei, J.G.; Huang, R.S.; Li, L.B. Endophytic fungi harbored in the root of Sophoraton kinensis Gapnep: Diversity and biocontrol potential against phytopathogens. Microbiol. Open 2017, 6, e00437. [Google Scholar] [CrossRef] [PubMed]
- Ogbonna, C.N.; Hideki Aoyag, H.; Ogbonna, J.C. Isolation and identification of Talaromyces purpurogenus and preliminary studies on its pigment production potentials in solid state cultures. Afr. J. Biotechnol. 2017, 16, 672–682. [Google Scholar] [CrossRef]
- Sembiring, M. Bacterial and Fungi Phosphate Solubilization Effect to Increase Nutrient Uptake and Potatoes (Solanum tuberosuml) Production on AndisolSinabung Area. J. Agron. 2017, 16, 131–137. [Google Scholar] [CrossRef][Green Version]
- Naraghi, L.; Heydari, A.; Rezaee, S.; Razavi, M. Biocontrol Agent Talaromyces flavus Stimulates the Growth of Cotton and Potato. J. Plant Growth Regul. 2012, 31, 471–477. [Google Scholar] [CrossRef]
- Hubbard, M.; Germida, J.J.; Vujanovic, V. Fungal endophytes enhance wheat heat and drought tolerance in terms of grain yield and second-generation seed viability. J. Appl. Microbiol. 2014, 116, 109–122. [Google Scholar] [CrossRef]
- Pavithra, G.; Bindal, S.; Rana, M.; Srivastava, S. Role of Endophytic Microbes Against Plant Pathogens. Asian J. Plant Sci. 2020, 19, 54–62. [Google Scholar] [CrossRef]
- Khalmuratova, I.; Kim, H.; Nam, Y.J.; Oh, Y.; Jeong, M.J.; Choi, H.R.; You, Y.H.; Choo, Y.S.; Lee, I.J.; Shin, J.H.; et al. Diversity and Plant Growth Promoting Capacity of Endophytic Fungi Associated with Halophytic Plants from the West Coast of Korea. Mycobiology 2015, 43, 373–383. [Google Scholar] [CrossRef] [PubMed]
- Shahzad, R.; Khan, A.L.; Al-Harrasi, A.; Kim, C.K.; Lee, I.J. Phytohormones enabled endophytic Penicillium funiculosum LHL06 protects Glycine max L. from synergistic toxicity of heavy metals by hormonal and stress-responsive proteins modulation. J. Hazard. Mater. 2019, 379, 120824. [Google Scholar] [CrossRef]
- Egamberdieva, D.; Wirth, S.J.; Alqarawi, A.A.; Abd_Allah, E.F.; Hashem, A. Phytohormones and Beneficial Microbes: Essential Components for Plants to Balance Stress and Fitness. Front. Microbiol. 2017, 8, 2104. [Google Scholar] [CrossRef]
- Khan, A.L.; Hamayun, M.; Kim, Y.-H.; Kang, S.M.; Lee, J.H.; Lee, I.N. Gibberellins producing endophytic Aspergillus fumigatus sp. LH02 influencedendogenous phytohormonal levels, isoflavonoids production and plant growth in salinity stress. Process. Biochem. 2010, 46, 440–447. [Google Scholar] [CrossRef]
- Hashem, A.; Abd_Allah, E.F.; Alqarawi, A.; Al-Huqail, A.A.; Wirth, S.; Egamberdieva, D. The interaction between arbuscular mycorrhizal fungi and endophytic bacteria enhances plant growth of Acacia gerrardii under salt stress. Front. Plant Sci. 2016, 7, 1089. [Google Scholar] [CrossRef]
- Bilal, S.; Shahzad, R.; Khan, A.L.; Kang, S.M.; Imran, Q.M.; Al-Harrasi, A.; Yun, B.W.; Lee, I.J. Endophytic Microbial Consortia of Phytohormones-Producing Fungus Paecilomyces formosus LHL10 and Bacteria Sphingomonas sp. LK11 to Glycine max L. Regulates Physio-hormonal Changes to Attenuate Aluminum and Zinc Stresses. Front. Plant Sci. 2018, 9, 1273. [Google Scholar] [CrossRef]
- Wongkoon, T.; Boonlue, S.; Riddech, N. Effect of compost made from filter cake and distillery slop on sugarcane growth. KKU Res. J. 2014, 19, 250–255. [Google Scholar]
- El-Tayeh, N.A.; Salama, F.M.; Loutfy, N.; Abou Alhamd, F.M. Effect of Sandy Soil Amendment with Filter Mud Cake on Growth and Some EcoPhysiological Parameters of Daucus carota and Beta vulgaris Plants. Catrina 2019, 18, 97–103. [Google Scholar] [CrossRef]
- Solaimalai, A.; Baskar, M.; Ramesh, P.T.; Ravisankar, N. Utilisation of Press Mud as Soil Amendment and Organic Manure—A review. Agric. Rev. 2001, 22, 25–32. [Google Scholar]
- Shen, M.; Liu, L.; Li, D.W.; Zhou, W.N.; Zhou, Z.P.; Zhang, C.F.; Luo, Y.Y.; Wang, H.B.; Li, H.Y. The effect of endophytic Peyronellaea from heavy metal-contaminated and uncontaminated siteson maize growth, heavy metal absorption and accumulation. Fungal Ecol. 2013, 6, 539–547. [Google Scholar] [CrossRef]
- Hakim, S.S.; Yuwati, T.W. The Use of Fungal Endophyte Penicillium citrinum on Tree Seedling: Applicability and Limitation. BIO Web Conf. 2020, 20, 03005. [Google Scholar] [CrossRef]
- Christie, P.; Li, X.; Chen, B. Arbuscular mycorrhiza can depress translocation of zinc to shoots of host plants in soils moderately polluted with zinc 2004. Plant Soil 2004, 261, 209–217. [Google Scholar] [CrossRef]
- Prasad, A.; Kumar, S.; Khaliq, A.; Pandey, A. Heavy metals and arbuscular mycorrhizal (AM) fungi can alter the yield and chemical composition of volatile oil of sweet basil (Ocimumbasilicum L.). Biol. Fertility Soils 2011, 47, 853. [Google Scholar] [CrossRef]
- Sabra, M.; Aboulnasr, A.; Franken, P.; Perreca, E.; Wright, L.P.; Camehl, I. Beneficial root endophytic fungi increase growth and quality parameters of weet basil in heavy metal contaminated soil. Front. Plant 2018, 9, 1726. [Google Scholar] [CrossRef] [PubMed]
- Sikander, A. Effect of Organic Manure and Inorganic Fertilizers on the Dynamics of Soil Microorganism: Biomass, Composition, and Activity. In Alternate/Organic Fertilizers; D8 Workshop: Islamabad, Pakistan, 2001. [Google Scholar]
- Yassen, A.A.; Khaled, S.M.; Zaghloul, S.M. Response of wheat to different rates and ratios of organic residues on yield and chemical composition under two types of soil. J. Am. Sci. 2010, 6, 858–864. [Google Scholar]
- Abo-Baker, A.A.; El-Tayeh, N.A. Heavy metal and phosphorus contents of Jew’s mallow (Corchorus olitorius L.) plants grown on soil amended with phosphate, bio and organic fertilizers. Int. J. Plant Soil Sci. 2017, 14, 1–19. [Google Scholar]
- Kabesh, M.O.; El-kramany, M.F.; Sary, G.A.; El-Naggar, H.M.; Bakhoum, G.S.H. Effect of sowing methods and some bio-organic fertilization treatments on yield and yield components of wheat. Res. J. Agric. Biol. Sci. 2009, 5, 97–102. [Google Scholar]
- Abo-Baker, A.A. Successive application impact of some organic amendments combined with acid producing bacteria on soil properties, NPK availability and uptake by some plants. Int. J. Curr. Microbiol. Appl. Sci. 2017, 6, 2394–2413. [Google Scholar] [CrossRef][Green Version]
- Ramoliya, P.J.; Patel, H.M.; Pandey, A.N. Effect of salinisation of soil on growth and macroand micro-nutrient accumulation in seedlings of Acacia catechu (Mimosaceae). Ann. Appl. Biol. 2004, 144, 321–332. [Google Scholar] [CrossRef]
- Abu Zuhri, K.M.B. The Environmental Impact of Sewage Sludge Application on Growth and Heavy Metals Uptake and Translocation in Sunflower and Sorghum Plants. Ph.D. Thesis, Faculty of Science, Assuit University, El Fateh, Egypt, 2004. [Google Scholar]
- Bhandal, I.S.; Malik, C.P. Potassium estimation, uptake, and its role in the physiology and metabolism of flowering plants. Int. Rev. Cytol. 1988, 110, 205–254. [Google Scholar]
- Blaha, G.; Stelzl, U.; Spahn, C.M.T.; Agrawal, R.K.; Frank, J.; Nierhaus, K.H. Preparation of functional ribosomal complexes and effect of buffer conditions on tRNA positions observed by cryoelectron microscopy. Methods Enzymol. 2000, 317, 292–309. [Google Scholar]
- Chiroma, T.M.; Ebewele, R.O.; Hymore, F.K. Comparative assessment of heavy metal levels in soil, vegetables and urban grey waste water used for irrigation in Yola and Kano. Int. Refereed J. Eng. Sci. 2014, 3, 1–9. [Google Scholar]
- Smith, S.R. Agricultural Recycling of Sewage Sludge and the Environment; CAB International: Boston, MA, USA, 1996. [Google Scholar]
- Gupta, A.K.; Sinha, S. Phytoextraction capacity of the plants growing on tannery sludge dumping sites. Bioresour. Technol. 2007, 98, 1788–1794. [Google Scholar] [CrossRef] [PubMed]
- Dussault, M.; Bécaert, V.; François, M.; Sauvé, S.; Deschênes, L. Effect of copper on soil functional stability measured by relative soil stability index (RSSI) based on two enzyme activities. Chemosphere 2008, 72, 755–762. [Google Scholar] [CrossRef]
- Cerqueira, B.; Vega, F.A.; Silva, L.F.O.; Andrade, L. Effects of vegetation on chemical and mineralogical characteristics of soils developed on a decantation bank from a copper mine. Sci. Total Environ. 2012, 421, 220–229. [Google Scholar] [CrossRef]
- Arenas-Lago, D.; Vega, F.A.; Silva, L.F.O.; Andrade, M.L. Soil interaction and fractionation of added cadmium in some Galician soils. Microchem. J. 2013, 110, 681–690. [Google Scholar] [CrossRef]
- Yang, X.E.; Li, T.Q.; Yang, J.C.; He, Z.L.; Lu, L.L.; Meng, F.H. Zinc compartmentation in root, transport into xylem, and absorption into leaf cells in the hyperaccumulating species of Sedum alfrediiHance. Planta 2006, 224, 185–195. [Google Scholar] [CrossRef] [PubMed]
- Brallier, S.; Harrison, R.B.; Henry, C.L.; Dongsen, X. Liming effects on availability of Cd, Cu, Ni, and Zn in a soil amended with sewage sludge 16 years previously. Water Air Soil Pollut. 1996, 86, 195–206. [Google Scholar] [CrossRef]
- Sloan, J.J.; Dowdy, R.H.; Dolan, M.S.; Linden, D.R. Long-term effects of biosolids applications on heavy metal bioavailability in agriculture soils. J. Environ. Qual. 1997, 26, 966–974. [Google Scholar] [CrossRef]
- Usman, A.R.A.; Kuzyakov, Y.; Stahr, K. Dynamic of organic C mineralization and the mobile fraction of heavy metals in a calcareous soil incubated with organic wastes. Water Air Soil Pollut. 2004, 158, 401–418. [Google Scholar] [CrossRef]
- Temminghoff, E.J.M.; van der Zee, S.E.A.T.M.; De Haan, F.A.M. Effects of dissolved organic matter on the mobility of copper in a contaminated sandy soil. Eur. J. Soil Sci. 1998, 49, 617–628. [Google Scholar] [CrossRef]
- Codex Alimentarius Commission (FAO/WHO). Food Additives and Contaminants-Joint; FAO/WHO: Rome, Italy, 2001; pp. 1–289. [Google Scholar]
- WHO. Permissible Limits of Heavy Metals in Soil and Plants; WHO: Geneva, Switzerland, 1996. [Google Scholar]
- Herman, D.; Artiola, J.; Miller, R. Removal of cadmium, lead and zinc from soil by a rhamnolipid biosurfactant. Environ. Sci. Technol. 1995, 29, 2280–2285. [Google Scholar] [CrossRef] [PubMed]
- Dubbin, W.E.; Louise Ander, E. Influence of microbial hydroxamate siderophores on Pb(II) desorption from α-FeOOH. Appl. Geol. Chem. 2003, 18, 1751–1756. [Google Scholar] [CrossRef]
- Di Simine, C.D.; Sayer, J.A.; Gadd, G.M. Solubilization of zinc phosphate by a strain of Pseudomonas fluorescence isolated from a forest soil. Biol. Fertil. Soils 1998, 28, 87–94. [Google Scholar] [CrossRef]
- Zhuang, X.; Chen, J.; Shim, H.; Bai, Z. New advances in plant growth promoting rhizobacteria for bioremediation. Environ. Int. 2007, 33, 406–413. [Google Scholar] [CrossRef]
- Khan, A.G. Mycorrhizoremediation—An enhanced from of phytoremediation. J. Zhejiang Univ. Sci. B 2007, 7, 503–514. [Google Scholar] [CrossRef] [PubMed]
- Lebeau, T.; Braud, A.; Jezeguel, K. Performance of augmentation assisted phytoextraction applied to metal contaminated soils: A review. Environ. Pollut. 2000, 153, 497–522. Available online: www.aseanenenvironment.info/abstract/41016970.pdf (accessed on 2 November 2021). [CrossRef]

| No | Treatments | Treatments Abbreviations |
|---|---|---|
| 1 | Sandy soil without sewage sludge and without endophytic fungus (100% sandy soil) | T1 |
| 2 | 75% soil + 25% sewage sludge | T2 |
| 3 | 50% soil +50% sewage sludge | T3 |
| 4 | 25% soil + 75% sewage sludge | T4 |
| 5 | 100% sandy soil + endophytic fungus as mentioned in Fungal Inoculum Preparation | T5 |
| 6 | 75% soil + 25% sewage sludge + endophytic fungus | T6 |
| 7 | 50% soil + 50% sewage sludge + endophytic fungus | T7 |
| 8 | 25% soil + 75% sewage sludge + endophytic fungus | T8 |
| No | Morphospecies | Strian | Sequence (bp) | Host | Location | GenBank Accessions |
|---|---|---|---|---|---|---|
| 1 | Talaromyces pinophilus | SVU3:83523 | 574 | Rosmarinus officinalis | Egypt | MW695526 |
| 2 | Talaromyces pinophilus | Y. H. Yeh I0609 | 595 | Ipomoea | Taiwan | MK336445 |
| 3 | Penicillium pinophilus | FKI-3864 | 596 | - | Japan | AB455516 |
| 4 | Talaromyces pinophilus | 17F4103 | 600 | - | Japan | MT093464 |
| 5 | Talaromyces pinophilus | Y. H. Yeh I0520 | 584 | Ipomoea | Taiwan | MK336630 |
| 6 | Talaromyces pinophilus | C.W. Hsieh CHD152 | 591 | Platostomapalustre | Taiwan | MH777072 |
| 7 | Talaromyces pinophilus | 1–95 | 6,009,755 | - | China | CP017345 |
| Treatment | Gibberellic Acid (μg mL−1) | Abscisic Acid (μg mL−1) |
|---|---|---|
| T1 | 4.11 | 3.05 |
| T2 | 0.41 | 0.09 |
| T3 | 2.11 | 2.19 |
| T4 | 0.00 | 0.00 |
| T5 | 2.00 | 5.14 |
| T6 | 5.36 | 0.00 |
| T7 | 2.78 | 0.00 |
| T8 | 5.22 | 7.13 |
| Treatments | T1 | T2 | T3 | T4 | T5 | T6 | T7 | T8 | |
|---|---|---|---|---|---|---|---|---|---|
| pH | Before | 8.15 f,* | 7.82 e | 7.57 d * | 7.56 d,* | 7.28 c | 6.86 b | 6.92 b | 6.46 a |
| After | 7.97 d | 7.63 c | 7.08 b | 6.91 ab | 6.72 a | 6.75 ab | 6.93 ab | 6.69 a | |
| OM (%) | Before | 2.73 a,* | 3.60 a * | 6.53 b,* | 8.44 c,* | 3.76 a,* | 5.74 b,* | 16.16 d,* | 22.52 e,* |
| After | 2.07 a | 2.87 b | 4.97 d | 6.18 f | 2.68 ab | 3.85 c | 12.72 g | 17.23 h | |
| Na (mg g−1) | Before | 1.73 a | 2.08 a | 3.54 b | 4.94 c | 1.05 a | 3.32 b,* | 9.58 e,* | 6.37 d,* |
| After | 1.16 a | 2.16 b | 3.07 c | 4.34 d | 0.84 a | 3.41 c | 6.65 e | 8.99 f | |
| K (mg g−1) | Before | 3.63 a | 6.04 b,* | 7.99 c,* | 9.52 d,* | 6.09 b,* | 10.14 d | 15.27 e | 25.29 f,* |
| After | 2.92 a | 4.85 b | 6.26 c | 7.13 cd | 3.59 ab | 8.28 d | 15.00 e | 19.23 f | |
| Ca (mg g−1) | Before | 7.12 a,* | 10.39 b,* | 14.38 c | 16.95 d,* | 13.10 c,* | 18.29 d,* | 20.80 e,* | 28.86 f,* |
| After | 4.96 a | 8.31 b | 10.63 d | 12.95 e | 9.65 c | 11.01 d | 16.01 f | 19.73 g | |
| Mg (mg g−1) | Before | 3.05 a,* | 4.09 b | 7.04 d | 8.74 e,* | 5.88 c | 9.75 f | 15.79 g,* | 19.24 h,* |
| After | 1.50 a | 3.20 ab | 4.74 b | 6.95 c | 4.20 b | 7.37 c | 10.13 d | 13.93 e | |
| Cd (µg g−1) | Before | 0.30 b | 0.58 c | 0.79 e | 1.00 f | 0.22 a,* | 0.32 b,* | 0.55 c,* | 0.70 d,* |
| After | 0.23 a | 0.53 b | 0.71 c | 0.93 d | 0.19 a | 0.24 a | 0.48 b | 0.55 b | |
| Cu (µg g−1) | Before | 10.44 d,* | 12.49 e,* | 18.94 f,* | 20.94 g,* | 4.90 a,* | 5.86 ab,* | 6.69 b,* | 9.05 c,* |
| After | 7.34 d | 10.27 e | 14.37 f | 15.18 f | 2.25 a | 3.57b | 5.05 c | 6.79 d | |
| Zn (µg g−1) | Before | 40.91 d,* | 45.44 f,* | 55.50 g,* | 77.21 h,* | 22.01 b,* | 20.19 a,* | 32.63 c,* | 43.92 e,* |
| After | 31.79 c | 29.78 c | 49.63 e | 70.49 f | 16.32 a | 14.17 a | 23.06b | 34.03d | |
| Ni (µg g−1) | Before | 26.85 d,* | 32.31 e,* | 43.23 f,* | 61.95 g,* | 13.54 a,* | 16.71 b,* | 20.72 c,* | 25.84 d,* |
| After | 21.78 d | 27.72 e | 36.12 f | 50.27 g | 10.78 a | 13.48 b | 16.62 c | 20.38 d | |
| Zn | Cd | Ni | Cu | |
|---|---|---|---|---|
| Bioconcentration factor (BCF) | ||||
| T1 | 0.958 | 0.689 | 0.363 | 0.435 |
| T2 | 1.410 | 0.790 | 0.424 | 0.633 |
| T3 | 1.289 | 0.832 | 0.391 | 0.497 |
| T4 | 1.438 | 0.804 | 0.334 | 0.527 |
| T5 | 2.111 | 0.769 | 0.690 | 0.869 |
| T6 | 2.613 | 1.116 | 0.714 | 0.889 |
| T7 | 1.892 | 0.813 | 0.641 | 0.939 |
| T8 | 1.861 | 0.670 | 0.489 | 0.531 |
| Translocation factor (TF) | ||||
| T1 | 0.264 | 0.752 | 1.022 | 0.536 |
| T2 | 0.613 | 0.768 | 0.660 | 0.886 |
| T3 | 0.683 | 0.720 | 0.832 | 1.081 |
| T4 | 0.755 | 0.953 | 0.722 | 0.528 |
| T5 | 0.597 | 0.895 | 1.015 | 0.464 |
| T6 | 0.729 | 0.501 | 0.643 | 0.708 |
| T7 | 0.524 | 0.894 | 0.729 | 0.918 |
Publisher’s Note: MDPI stays neutral with regard to jurisdictional claims in published maps and institutional affiliations. |
© 2021 by the authors. Licensee MDPI, Basel, Switzerland. This article is an open access article distributed under the terms and conditions of the Creative Commons Attribution (CC BY) license (https://creativecommons.org/licenses/by/4.0/).
Share and Cite
El-Shahir, A.A.; El-Tayeh, N.A.; Ali, O.M.; Abdel Latef, A.A.H.; Loutfy, N. The Effect of Endophytic Talaromyces pinophilus on Growth, Absorption and Accumulation of Heavy Metals of Triticum aestivum Grown on Sandy Soil Amended by Sewage Sludge. Plants 2021, 10, 2659. https://doi.org/10.3390/plants10122659
El-Shahir AA, El-Tayeh NA, Ali OM, Abdel Latef AAH, Loutfy N. The Effect of Endophytic Talaromyces pinophilus on Growth, Absorption and Accumulation of Heavy Metals of Triticum aestivum Grown on Sandy Soil Amended by Sewage Sludge. Plants. 2021; 10(12):2659. https://doi.org/10.3390/plants10122659
Chicago/Turabian StyleEl-Shahir, Amany A., Noha A. El-Tayeh, Omar M. Ali, Arafat Abdel Hamed Abdel Latef, and Naglaa Loutfy. 2021. "The Effect of Endophytic Talaromyces pinophilus on Growth, Absorption and Accumulation of Heavy Metals of Triticum aestivum Grown on Sandy Soil Amended by Sewage Sludge" Plants 10, no. 12: 2659. https://doi.org/10.3390/plants10122659
APA StyleEl-Shahir, A. A., El-Tayeh, N. A., Ali, O. M., Abdel Latef, A. A. H., & Loutfy, N. (2021). The Effect of Endophytic Talaromyces pinophilus on Growth, Absorption and Accumulation of Heavy Metals of Triticum aestivum Grown on Sandy Soil Amended by Sewage Sludge. Plants, 10(12), 2659. https://doi.org/10.3390/plants10122659

